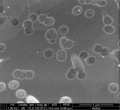

Ciencia de los Materiales
Materiales 10 veces más ligeros que los compuestos de fibra de carbono
Una nueva técnica recién desarrollada permitirá procesar nanotubos de carbono de la manera adecuada para usarlos en materiales compuestos más fuertes y/o más livianos, capaces de reemplazar a diversos materiales hoy usados en estructuras críticas de infinidad de vehículos y otros objetos, desde aviones hasta bicicletas.
Actualmente se usan sofisticados compuestos de fibra de carbono en la construcción de aviones y otros productos donde son cruciales los materiales fuertes y ligeros. Por ejemplo, los aviones con menor peso son más eficientes en la utilización del combustible. Sin embargo, ya hace tiempo que los científicos están ilusionados con la perspectiva de que si estos compuestos pudieran hacerse con nanotubos de carbono, podrían ser por lo menos 10 veces más ligeros, o podrían tener el mismo peso pero ser 10 veces más fuertes.
Para crear un material compuesto robusto a base de nanotubos de carbono se requieren cuatro características. Primero, se necesitan nanotubos de carbono largos, los cuales son más eficaces para aguantar peso. Segundo, los nanotubos de carbono necesitan ser alineados en filas. Tercero, los nanotubos de carbono en el material deben ser unidos por un polímero o resina, pero se necesita mantener una alta proporción de nanotubos de carbono con respecto al polímero en el material compuesto acabado. Cuarto, se necesita que los nanotubos de carbono sean lo más rectos posible, para que el material soporte el peso de la manera más uniforme posible.![[Img #10714]](upload/img/periodico/img_10714.jpg)
Durante décadas los investigadores fueron incapaces de lograr estos objetivos. Pero ahora, un equipo de investigación dirigido por Yuntian Zhu, profesor de ciencia e ingeniería de los materiales en la Universidad Estatal de Carolina del Norte, ha desarrollado una técnica que permite procesar apropiadamente los nanotubos de carbono antes de incorporarlos en un material compuesto. Con esta técnica, se mejora la conductividad eléctrica y térmica del material compuesto, así como otras de sus características.
En el trabajo de investigación y desarrollo también han intervenido especialistas del Instituto de Nanotecnología y Nanobiónica de Suzhou en China, la Universidad Donghua en Shangai, China, y tres instituciones estadounidenses: el Laboratorio Nacional de Oak Ridge (ORNL) en Tennessee, el Centro Marshall de Vuelos Espaciales de la NASA en Huntsville, Alabama, y el Laboratorio Nacional de Los Álamos en Nuevo México.
Información adicional